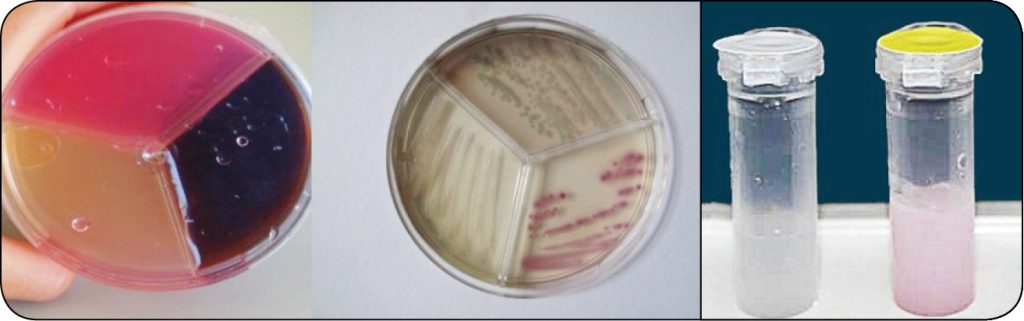
WWT_4_24_bydlo_Sebastian_Smulski_DIAGNOSTYKA_PATOGENOW_MASTITIS_RYC_1

Nowoczesne metody diagnostyki patogenów mastitis
Podłoża agarowe
Najpopularniejsze wciąż pozostają podłoża agarowe, ze względu na ich przystępną cenę (Columbia agar, agar z krwią, podłoże Edwardsa, Sabouraud agar, podłoże Chapmana, BA agar, McConkey agar itd.). Do sprawnego rozpoznania wymagana jest wiedza mikrobiologiczna na takim poziomie, że trudno je realizować w warunkach lecznicowych, a tym bardziej fermowych. Zwykle jest to powód, dla którego tylko w niewielu miejscach poza laboratorium wymienione podłoża są używane. Wytyczne do diagnostyki patogenów mastitis opierają się wciąż na wymienionych podstawowych podłożach agarowych (5).
Dużym ułatwieniem pozostają podłoża selektywne (Vetorapid, CM test, Mastdecide, Mastatest itd.), dzięki którym można w ciągu 8-24 h postawić rozpoznanie bakteriologiczne (ryc. 1).
Podłoża tego typu są przeznaczone do diagnostyki patogenów z każdego świeżego przypadku. Ich czułość waha się między 70-90%, a swoistość – na poziomie 80-90%. Należy mieć świadomość, że dokładność rozpoznania jest zdecydowanie mniejsza niż diagnostyki laboratoryjnej. Z drugiej strony, mimo wszystko taki wynik pozwala precyzyjniej dobrać leczenie danej krowy w porównaniu z leczeniem w „ciemno”.
MALDI-TOF MS
System MALDI-TOF MS identyfikuje za pomocą pomiaru unikatowych białek. Białka te znajdują się w każdym organizmie i są jego „odciskiem palca”. [...]
którzy są subskrybentami naszego portalu.
i ciesz się dostępem do bazy merytorycznej wiedzy!
POSTĘPOWANIA
w weterynarii



